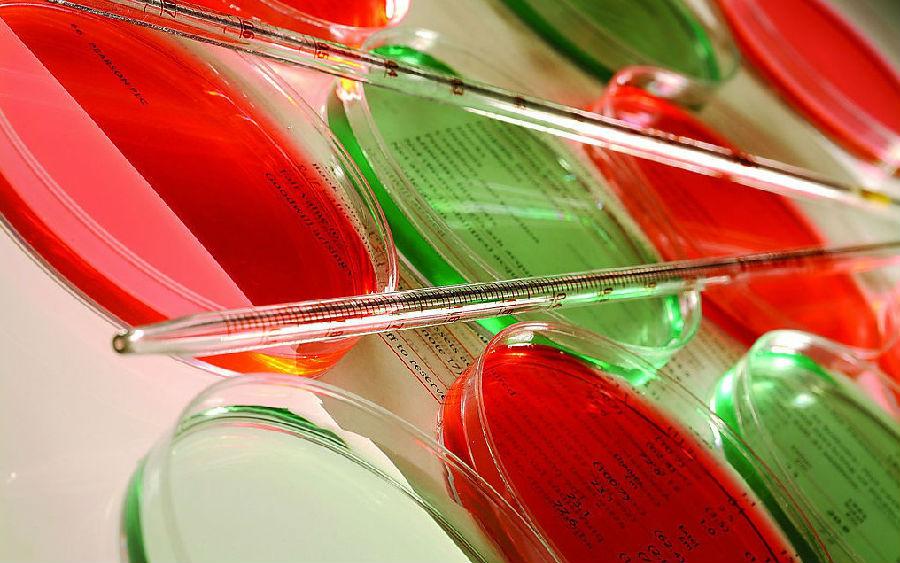

世界面临改变
上一节
下一节
世界面临改变
随着社会经济的发展,人类不断面临新的问题。在找到热能、电能之后又面临劳动力的失业;在解决温饱问题之后,又面临人口过度增加;在利用煤炭、石油后出现了温室效应;发明制造新化合物时会增加环境污染;发现核能后则进入了热核军备竞争;建立基因重组技术后,出现了生物武器;有了克隆技术会失去生物多样性等等。